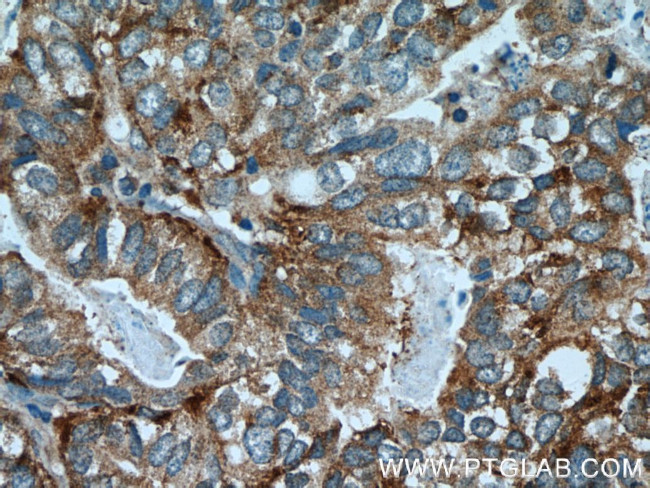
AGA Antibody in Immunohistochemistry (Paraffin) (IHC (P))

Search
Proteintech
AGA Polyclonal Antibody
{{$productOrderCtrl.translations['antibody.pdp.commerceCard.promotion.promotions']}}
{{$productOrderCtrl.translations['antibody.pdp.commerceCard.promotion.viewpromo']}}
{{$productOrderCtrl.translations['antibody.pdp.commerceCard.promotion.promocode']}}: {{promo.promoCode}} {{promo.promoTitle}} {{promo.promoDescription}}. {{$productOrderCtrl.translations['antibody.pdp.commerceCard.promotion.learnmore']}}
产品信息
17299-1-AP
种属反应
宿主/亚型
分类
类型
抗原
偶联物
形式
浓度
规格
纯化类型
保存液
内含物
保存条件
运输条件
产品详细信息
Immunogen sequence: MARKSNLPV LLVPFLLCQA LVRCSSPLPL VVNTWPFKNA TEAAWRALAS GGSALDAVES GCAMCEREQC DGSVGFGGSP DELGETTLDA MIMDGTTMDV GAVGDLRRIK NAIGVARKVL EHTTHTLLVG ESATTFAQSM GFINEDLSTS ASQALHSDWL ARNCQPNYWR NVIPDPSKYC GPYKPPGILK QDIPIHKETE DDRGHDTIGM VVIHKTGHIA AGTSTNGIKF KIHGRVGDSP IPGAGAYADD TAGAAAATGN GDILMRFLPS YQAVEYMRRG EDPTIACQKV ISRIQKHFPE FFGAVICANV TGSYGAACNK LSTFTQFSFM VYNSEKNQPT EEKVDCI (1-346 aa encoded by BC012392)
靶标信息
Aspartylglucosaminidase is involved in the catabolism of N-linked oligosaccharides of glycoproteins. It cleaves asparagine from N-acetylglucosamines as one of the final steps in the lysosomal breakdown of glycoproteins. The lysosomal storage disease aspartylglycosaminuria is caused by a deficiency in the AGA enzyme. Alternatively spliced transcript variants have been identified.
仅用于科研。不用于诊断过程。未经明确授权不得转售。
生物信息学
蛋白别名: AGA; Aspartylglucosaminidase; aspartylglucosylamine deaspartylase; Glycosylasparaginase; mutated glycoasparaginase gene, deletion at bp 29; N(4)-(Beta-N-acetylglucosaminyl)-L-asparaginase; N4-(N-acetyl-beta-glucosaminyl)-L-asparagine amidase; unnamed protein product
基因别名: AGA; AGU; ASRG; AW060726; GA
UniProt ID: (Human) P20933, (Rat) P30919, (Mouse) Q64191
Entrez Gene ID: (Human) 175, (Rat) 290923, (Mouse) 11593